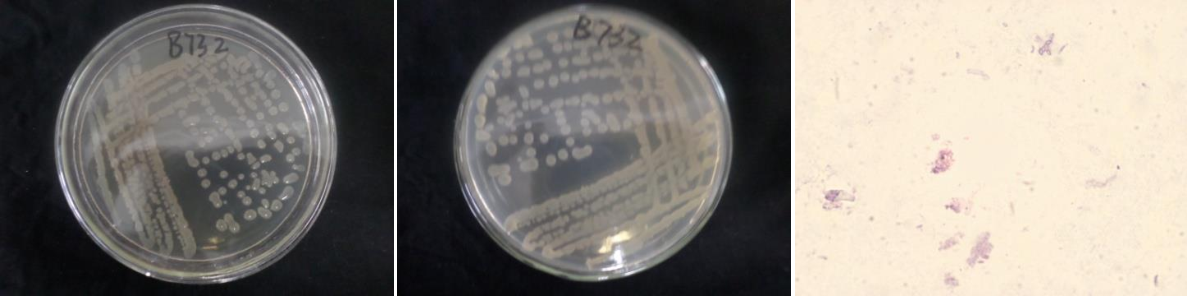

Loading...
| StrainNO | B732 |
| Classification | Bacillus |
| 16s rDNA sequence | GGAGATTGCGGCCTGCTTACCATGCAGTCGAACGATGAAGCCCAGCTTGCTGGGTGGATTAGTGGCGAACGGGTGAGTAACACG TGAGTAACCTGCCCTTGACTCTAGGATAAGCCCGGGAAACTGGGTCTAATACTGGATAGGAACGTCTACCGCATGGTGGATGTT GGAAAGAATTTCGGTCATGGATGGACTCGCGGCCTATCAGCTTGTTGGTGAGGTAATGGCTCACCAAGGCGACGACGGGTAGCC GGCCTGAGAGGGTGACCGGCCACACTGGGACTGAGACACGGCCCAGACTCCTACGGGAGGCAGCAGTGGGGAATATTGCACAAT GGGCGAAAGCCTGATGCAGCGACGCCGCGTGAGGGATGACGGCCTTCGGGTTGTAAACCTCTTTCAGTAGGGAAGAAGCGAAAG TGACGGTACCTGCAGAAGAAGCACCGGCTAACTACGTGCCAGCAGCCGCGGTAATACGTAGGGTGCGAGCGTTATCCGGAATTA TTGGGCGTAAAGAGCTCGTAGGCGGTTTGTCGCGTCTGTCGTGAAAGTCCGGGGCTTAACCCCGGATCTGCGGTGGGTACGGGC AGACTAGAGTGCAGTAGGGGAGACTGGAATTCCTGGTGTAGCGGTGGAATGCGCAGATATCAGGAGGAACACCGATGGCGAAGG CAGGTCTCTGGGCTGTAACTGACGCTGAGGAGCGAAAGCATGGGGAGCGAACAGGATTAGATACCCTGGTAGTCCATGCCGTAA ACGTTGGGCACTAGGTGTGGGGAACATTCCACGTTTTCCGCGCCGCAGCTAACGCATTAAGTGCCCCGCCTGGGGAGTACGGCC GCAAGGCTAAAACTCAAAGGAATTGACGGGGGCCCGCACAAGCGGCGGAGCATGCGGATTAATTCGATGCAACGCGAAGAACCT TACCAAGGCTTGACATGTTCTCGATCGCCGTAGAGATACGGTTTCCCCTTTGGGGCGGGTTCACAGGTGGTGCATGGTTGTCGT CAGCTCGTGTCGTGAGATGTTGGGTTAAGTCCCGCAACGAGCGCAACCCTCGTTCCATGTTGCCAGCACTTCGGGTGGGGACTC ATGGGAGACTGCCGGGGTCAACTCGGAGGAAGGTGGGGACGACGTCAAATCATCATGCCCCTTATGTCTTGGGCTTCACGCATGCTACAATGGCCGGTACAATGGGTTGCGATACTGTGAGGTGGAGCTAATCCCAAAAAGCCGGTCTCAGTTCGGATTGGGGTCTGC AACTCGACCCCATGAAGTCGGAGTCGCTAGTAATCGCAGATCAGCAACGCTGCGGTGAATACGTTCCCGGGCCTTGTACACACC GCCCGTCAAGTCACGAAAGTCGGTAACACCCGAAGCCGGTGGCCTAACCCTTGTGGAGGGAGCCGTCGAAGGTGACCAAGGGG |
| Strain Morphology Photos | |
| Morphological Description | The morphology of Colony round;lychee white;edge neatly;steamed bun shaped;concentric ring;slightly convex;slippy;sticky;The morphology of strain:Rod;having spore;spore mesophytic |